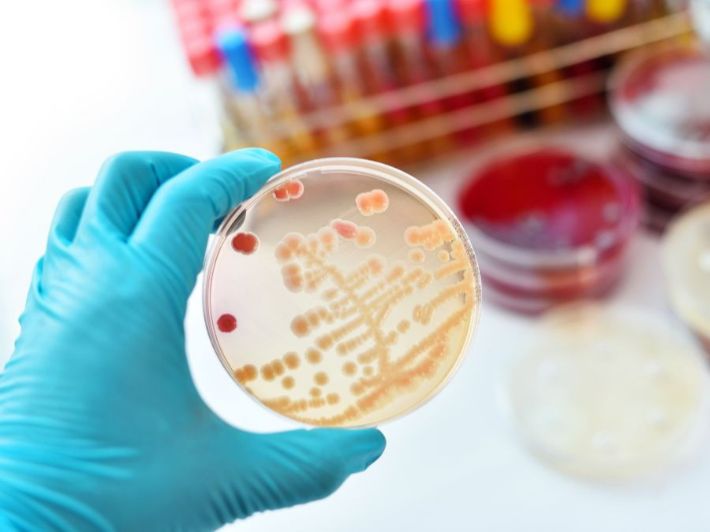
أعراض بكتيريا المكورات العقدية

تُسبِّب بكتيريا المكورات العقدية (Streptococcal infection) التهاباتٍ بكتيرية، تختلف أعراضها باختلاف الفصيلة البكتيرية المُسبِّبة للعدوى، وهو ما سنتطرّق إليه بالتفصيل في المقال.[١]
أعراض بكتيريا المكورات العقدية
هنالك نوعان من بكتيريا المكورات العقدية؛ وهما المكوّرات العقدية أ والمكوّرات العقدية ب،[٢] بحيث تتمثّل الأعراض بالتفصيل لكلّ منهما كما يلي:
أعراض بكتيريا المكوّرات العقدية أ
تُسبِّب بكتيريا المكوّرات العقدية أ الالتهابات التي تتراوح ما بين البسيطة في الجلد أو الالتهابات المُهدِّدة للحياة،[٣] كالتهاب الحلق، أو الحمّى القرمزية، أو متلازمة الصّدمة السامة، أو التهاب النسيج الخلوي ومرض أكل اللحم،[٢] وفيما يلي تفصيلٌ لأعراض هذه الالتهابات:[٤][٥]
- التهاب الحلق والبلعوم: متمثّلاً بتورّم الغدد اللمفاوية في منطقة الرقبة والانزعاج وصعوبة البلع وتشكل القيح في اللوزتين.
- القوباء: هي عدوى بكتيرية تصيب الجلد، فتُسبِّب تشكّل تقرّحات وبثور وقشور على الجلد.
- التهاب النسيج الخلوي: هي عدوى بكتيرية تصيب طبقات الجلد العميقة، فتصبح بعض المناطق حمراء ومثيرةً للألم، ومنتفخة ومتورّمة وساخنة على نحوٍ سريع.
- التهاب الأذن الوسطى: مُسبِّبةً ألم الأذن وارتفاع درجة حرارة الجسم وفقدان السّمع المؤقت.
- التهاب الجيوب الأنفية: والمُتسبِّب بانسداد أو احتقان وسيلان الأنف، أو ألم نابض في الوجه.
- الحمّى القرمزية: هي عدوى متمثِّلة بطفح جلدي أحمر أو وردي على الصّدر والبطن ومن ثمّ ستنتشر إلى باقي أنحاء الجسم، فتكون ذات ملمسٍ ناعم يُشبه ورق الصّنفرة عند لمسه.
- الالتهاب الرئوي: وهي عدوى تصيب الرّئتين، مُسبِّبةً السّعال المستمرّ وصعوبة التنفس، وألم الصّدر.
- تسمّم الدم: هي عدوى تصيب الدم، مُسبِّبةً الحمّى وتسارع نبضات القلب ومعدّل التنفس.
- التهاب السّحايا: هي عدوى تصيب الأغشية المحيطة بالدّماغ والحبل الشوكي، مُسبِّبةً الصّداع، والغثيان، والتّقيؤ، وتصلّب أو تيبّس الرّقبة، والتّحسّس من الأضواء السّاطعة، وطفح جلدي.
- متلازمة الصّدمة السّامة: وهي العدوى التي تطلق البكتيريا سمومها في الدم، مُسبِّبةً ارتفاعًا في درجة حرارة الجسم، والغثيان والتّقيؤ، والإسهال والدّوخة والارتباك والإغماء.
- مرض أكل اللحم: هي عدوى تصيب طبقات الجلد العميقة، وصولاً إلى الدّهون والعضلات، ومُسبِّبةً ألمًا شديدًا، وتورّمًا، واحمرارًا في المنطقة المُصابة.
تعدّ بكتيريا المكوّرات العقدية النوع أ الأكثر خطورةً بالمقارنة مع بكتيريا المكوّرات العقدية النوع ب.
أعراض بكتيريا المكوّرات العقدية ب
تُسبِّب بكتيريا المكوّرات العقدية ب التهابات الدم والالتهاب الرّئوي والتهاب السّحايا عند الأطفال حديثي الولادة،[٢] أو التهابات المسالك البولية، أو بعض التهابات الجلد، والعظام، والرئة، ويكون كبار السّن ومصابو السّكري هم الأكثر عرضةً للإصابة بها،[٤] إذ تشمل أعراض هذه العدوى ما يلي:[١]
- رفض الطّفل للرضاعة.
- الحمّى، أو انخفاض درجة حرارة الجسم على نحوٍ غير اعتيادي.
- تسارع نبضات القلب أو تباطؤها.
كيف تنتشر بكتيريا المكورات العقدية؟
تنتشر بكتيريا المكوّرات العقدية من خلال أحد الطّرق التالية:[٦]
- التّلامس مع شخصٍ مُصاب بالعدوى البكتيرية.
- قطرات السّعال أو العطاس لشخصٍ مُصاب بعدوى بكتيريا المكورات العقدية.
- تناول طعام أو شراب ملوّث بالبكتيريا؛ كالألبان أو الأجبان أو البيض أو الحليب.
- تلوّث الجروح أو الخدوش المفتوحة في الجلد.
المراجع
- ^ أ ب infections are any type,are primarily treated with antibiotics?. "What are Streptococcal infections?", www.yourgenome.org, Retrieved 13/3/2022. Edited.
- ^ أ ب ت "Streptococcal Infections", medlineplus.gov, Retrieved 13/3/2022. Edited.
- ↑ "Group A Streptococcal Infections", my.clevelandclinic.org, Retrieved 13/3/2022. Edited.
- ^ أ ب "Streptococcal infections", 111.wales.nhs.uk, Retrieved 13/3/2022. Edited.
- ↑ "Streptococcal Infections", www.msdmanuals.com, Retrieved 13/3/2022. Edited.
- ↑ "Streptococcal infections: important information", www.nhsborders.scot.nhs.uk, Retrieved 13/3/2022. Edited.